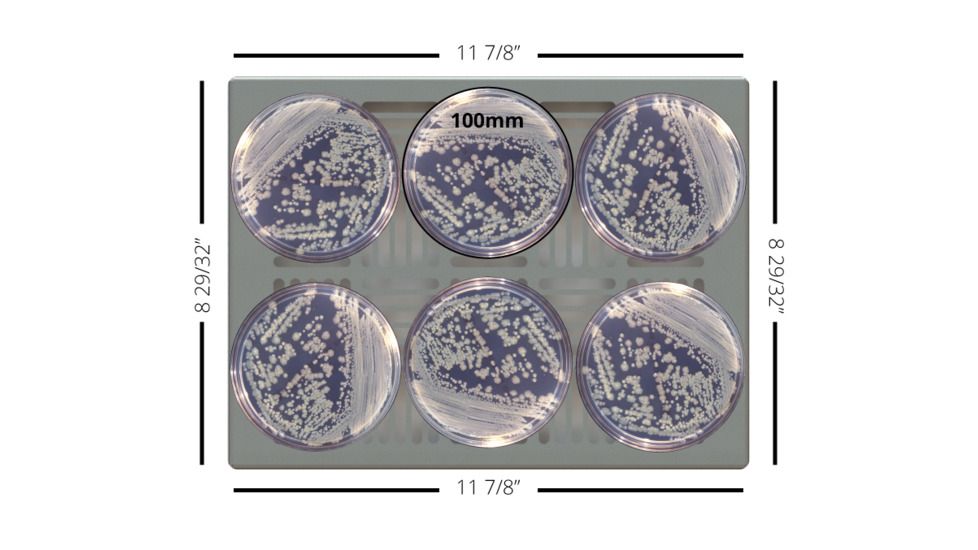
LW Scientific USA Incubator - 10L (.35 cu.ft.) - 65C (150F) - Digital, 110v AC ICL-010L-D031

Tap Tap to Zoom
LW Scientific USA digital incubators are engineered, designed and assembled in Atlanta. The PDI microprocessor controls provide great temperature stability and accuracy and the convection heating delivers even temperatures throughout the incubator. Constructed of Aluminum and Stainless Steel they are corrosion resistant and easy to clean. Applications include microbiological cultures, egg incubation, clinical test kit development, fluid bag warming. . . Perfect for physician, hospital, pediatric, and veterinary labs.![]()
We have professionals with many years of lab experience ready to reply to your emails and phone inquiries. You may request quotes together with shipping info for overseas orders or freight shipped items. We have many ways to order which include credit card, Pay pal, and bank wire transfer (EFT), additionally we accept purchase orders at net thirty terms. Remember when you require Constant Temperature Equipment and need it right now we are here to assist.
| Temperature Range: | Ambient +2°C to 65°C |
| Accuracy: | +/- 0.5°C |
| Power: | 300 watt/115v AC |